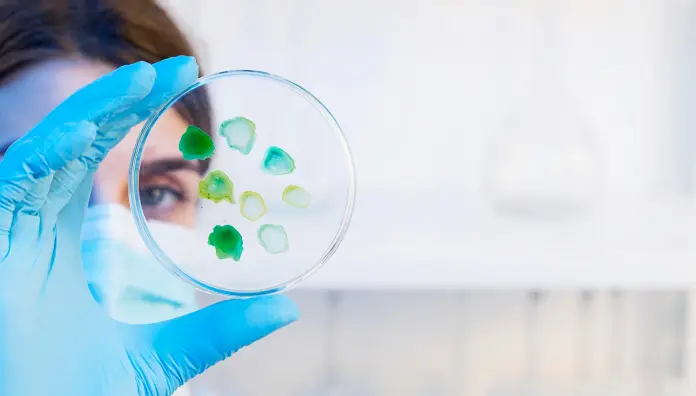
Régimen de control en materia de inversiones extranjeras. Impacto en el sector de la salud

No te pierdas nuestros contenidos
SuscribirmeNo te pierdas nuestros contenidos
Suscribirme
No te pierdas nuestros contenidos
SuscribirmeNo te pierdas nuestros contenidos
SuscribirmeRecibe en tu email el contenido jurídico que te interesa
Personaliza tus intereses y accede a un mundo de conocimiento jurídico:
Escoge tus interesesCuatrecasas utiliza cookies propias y de terceros para permitir el correcto funcionamiento de la web y analizar el uso, lo que nos ayuda a realizar mejoras midiendo cómo utiliza el sitio. Puede aceptar, rechazar o configurar el uso de cookies seleccionando en los botones a continuación. Más información en Política de cookies.
Son aquellas que permiten al usuario la navegación a través de la página web y la utilización de las diferentes opciones o servicios, incluyendo aquellas que se utilizan para permitir la gestión y operativa de la página web y habilitar sus funciones y servicios. La web no puede funcionar correctamente sin estas cookies.
Las cookies de preferencias permiten que un sitio web recuerde información que cambia la forma en que se comporta o se ve el sitio web, como su idioma preferido o la región en la que se encuentra.
Son aquellas que permiten el seguimiento y análisis del comportamiento de los usuarios en el sitio web. La información recogida mediante este tipo de cookies se utiliza en la medición de la actividad del sitio web con el fin de introducir mejoras en función del análisis de los datos de uso que hacen los usuarios del servicio.